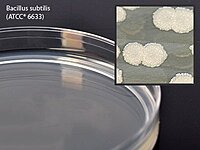
Mueller Hinton Agar Prepared Media Dehydrated (PK/10EA) Mueller Hinton Agar Prepared Media Dehydrated (PK/10EA)

Mueller Hinton Agar Prepared Media Dehydrated (PK/10EA)
Choose Quantity
Mueller Hinton Agar Prepared Media Dehydrated (PK/10EA)
Mueller Hinton Agar Prepared Media Dehydrated is designed for laboratory and microbiology applications in professional testing environments. This dehydrated prepared media format supports organized microbiology workflow and standardized supply stocking.
Packaged 10 per pack, this product is suitable for laboratory environments, diagnostic support programs, microbiology workflows, and educational lab settings where prepared media products are maintained.
Key Features:
• Prepared media
• Mueller Hinton Agar
• Dehydrated format
• Suitable for laboratory and microbiology applications
• Pack contains 10 units
Benefits:
• Supports standardized microbiology workflow
• Suitable for laboratory and diagnostic supply programs
• Pack quantity supports organized replenishment
• Appropriate for specialty testing environments
Specifications:
• Product Type: Prepared Media
• Media Type: Mueller Hinton Agar
• Format: Dehydrated
• Minimum Selling/Purchasing Unit: PK
• Minimum Package Qty: 10 Each
• Packaging: PK/10EA
• MPN: G60
Application:
Prepared media products are used in laboratory and microbiology environments where testing and culture workflows are maintained.
Common applications include:
• Microbiology laboratories
• Diagnostic support settings
• Educational laboratory environments
• Specialty testing workflows
Use according to product labeling and laboratory protocol.
Warnings:
• For professional laboratory use
• Use according to product labeling and facility procedures
• Inspect packaging before use
• Store according to labeled handling requirements






